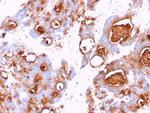
Carcinoembryonic Antigen (CEA)/CD66 Antibody in Immunohistochemistry (Paraffin) (IHC (P))

Search
NeoBiotechnologies
Carcinoembryonic Antigen (CEA)/CD66 Monoclonal Antibody (CEA31)
{{$productOrderCtrl.translations['antibody.pdp.commerceCard.promotion.promotions']}}
{{$productOrderCtrl.translations['antibody.pdp.commerceCard.promotion.viewpromo']}}
{{$productOrderCtrl.translations['antibody.pdp.commerceCard.promotion.promocode']}}: {{promo.promoCode}} {{promo.promoTitle}} {{promo.promoDescription}}. {{$productOrderCtrl.translations['antibody.pdp.commerceCard.promotion.learnmore']}}
产品信息
1048-MSM4-P0
种属反应
宿主/亚型
分类
类型
克隆号
抗原
偶联物
形式
浓度
规格
纯化类型
保存液
内含物
保存条件
运输条件
靶标信息
The CD66 molecules are 180-200 kDa glycoproteins of carcinoembryonic antigen family. They are present on all blood granulocytes and some tissue macrophages, but are absent from other hematopoietic cells. The expression of CD66 increases significantly on granulocytes upon their activation. CD66a (BGP1, CEACAM1) and CD66d (CGM1, CEACAM3), as well as CEACAM2 and 4, are transmembrane proteins, whereas CD66c (CEAL, NCA, CEACAM6) and CD66e (CEA, CEACAM5), as well as CEACAM7 and 8, are anchored to the plasma membrane by C-terminal glycosylphosphatidylinositol (GPI) lipid moiety.
仅用于科研。不用于诊断过程。未经明确授权不得转售。
篇参考文献 (0)
生物信息学
蛋白别名: antigen CD66; BGP; BGP-1; Biliary glycoprotein 1; biliary glycoprotein adhesion molecule; biliary glycoprotein I precursor; carcinoembronyic antigen; Carcinoembryonic antigen; Carcinoembryonic antigen CGM1; Carcinoembryonic antigen CGM7; carcinoembryonic antigen gene family member 1; carcinoembryonic antigen gene family member 7; carcinoembryonic antigen precursor; carcinoembryonic antigen related cell adhesion molecule 1; carcinoembryonic antigen related cell adhesion molecule 3; carcinoembryonic antigen related cell adhesion molecule 4; carcinoembryonic antigen related cell adhesion molecule 5; carcinoembryonic antigen related cell adhesion molecule 6; Carcinoembryonic antigen-related cell adhesion molecule 1; carcinoembryonic antigen-related cell adhesion molecule 1 (biliary glycoprotein); Carcinoembryonic antigen-related cell adhesion molecule 3; Carcinoembryonic antigen-related cell adhesion molecule 4; carcinoembryonic antigen-related cell adhesion molecule 4-sv1; carcinoembryonic antigen-related cell adhesion molecule 4-sv2; Carcinoembryonic antigen-related cell adhesion molecule 5; Carcinoembryonic antigen-related cell adhesion molecule 6; carcinoembryonic antigen-related cell adhesion molecule 6 (non-specific cross reacting antigen); CD66a; CD66a antigen; CD66c; CD66d; CD66d antigen; CD66e; CEA; CEA cell adhesion molecule 1; CEA cell adhesion molecule 3; CEA cell adhesion molecule 4; CEA cell adhesion molecule 5; CEA cell adhesion molecule 6; CEACAM-1; CEACAM-3; CEACAM-5; CEACAM-6; CEACAM1-3S; Cell adhesion molecule CEACAM1; Cell adhesion molecule CEACAM3; Cell adhesion molecule CEACAM4; Cell adhesion molecule CEACAM5; Cell adhesion molecule CEACAM6; Cluster of Differentiation 66c; Meconium antigen 100; Non-specific cross-reacting antigen W236; Non-specific crossreacting antigen; nonspecific cross-reacting antigen; Nonspecific cross-reacting antigen (NCA); nonspecific cross-reacting antigen W236; nonspecific crossreacting antigen precursor; Normal cross-reacting antigen; ORF1; ORF2; pan CEACAM; unnamed protein product
基因别名: BGP; BGP1; BGPI; CD66c; CD66D; CD66e; CEA; CEACAM1; CEACAM3; CEACAM4; CEACAM5; CEACAM6; CEAL; CGM1; CGM1a; CGM7; CGM7_HUMAN; NCA; NCA-50/90; W264; W282
UniProt ID: (Human) P13688, (Human) P40198, (Human) O75871, (Human) P06731, (Human) P40199
Entrez Gene ID: (Human) 634, (Human) 1084, (Human) 1089, (Human) 1048, (Human) 4680